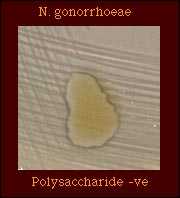
polysaccharide

Characteristics of N. gonorrhoeae and Related Species of Human Origin
Introduction
Because investigations of sexual abuse may be initiated on the basis of a laboratory diagnosis of gonorrhea, it is important that only strains of N. gonorrhoeae be identified and reported as N. gonorrhoeae.
Several Neisseria and related species may be misidentified as N. gonorrhoeae unless appropriate differential tests are performed. The purpose of this, and other, pages in this section is to provide information, including illustrations, of characteristics of N. gonorrhoeae that may aid in differentiating between N. gonorrhoeae and related species. This page is designed to provide information relating to the accurate identification of N. gonorrhoeae and will include not only traditional tests for the identification of this species but also discussions of rapid tests, problems associated with the tests, and the additional tests should be performed to identify a gram-negative, oxidase-positive diplococcal strain.
Definitions: Identification of N. gonorrhoeae
Because of the serious social and medicolegal consequences of misdiagnosing gonorrhea or misidentifying strains of N. gonorrhoeae, the CDC has recommended criteria for reporting diagnoses of gonorrhea (15). Three levels of diagnosis are defined on the basis of clinical findings or the results of laboratory diagnostic tests. A definitive diagnosis of gonorrhea must be obtained for medicolegal purposes.
A Suggestive diagnosis is defined by the presence of:
- a mucopurulent endocervical or urethral exudate on physical examination and
- sexual exposure to a person infected with N. gonorrhoeae.
A Presumptive diagnosis of gonorrhea is made on the basis of one of the following three criteria:
- typical gram-negative intracellular diplococci on microscopic examination of a smear of urethral exudate from men or endocervical secretions from women*;
- growth of a gram-negative, oxidase-positive diplococcus, from the urethra (men) or endocervix (women), on a selective culture medium, and demonstration of typical colonial morphology, positive oxidase reaction, and typical gram- negative morphology;
- detection of N. gonorrhoeae by a nonculture laboratory test (Antigen detection test (e.g., Gonozyme [Abbott]), direct specimen nucleic acid probe test (e.g., Pace II [GenProbe]), nucleic acid amplification test (e.g., LCR [Abbott]).
* The observation of gram-negative, intracellular diplococci on microscopic examination of endocervical secretions from women must be supported by a positive result from a test from either 2 or 3 to make a laboratory diagnosis of “presumptive N. gonorrhoeae.”
A Definitive diagnosis of gonorrhea requires:
- isolation of N. gonorrhoeae from sites of exposure (e.g., urethra, endocervix, throat, rectum) by culture (usually a selective medium) and demonstrating typical colonial morphology, positive oxidase reaction, and typical gram-negative morphology and
- confirmation of isolates by biochemical, enzymatic, serologic, or nucleic acid testing e.g., carbohydrate utilization, rapid enzyme substrate tests, serologic methods such as coagglutination or fluorescent antibody tests supplemented with additional tests that will ensure accurate identification of isolates, or a DNA probe culture confirmation technique.
It should be noted that these definitions, which are intended for clinical care, are much more precisely worded than those of the Case Definition of gonorrhea intended for Public Health Surveillance purposes.
Table 1. Characteristics of N. gonorrhoeae
| Characteristic | Illustration |
|---|---|
| Gram stain Cell Morphology | Gram-negative diplococcus |
Freshly isolated strains of N. gonorrhoeae exhibit at least two of four colony forms, designated T1, T2, T3, and T4. T1 colonies predominate in the first culture of an isolate; in subsequent subcultures, T3 colonies predominate and T1 colonies may not be observed. Gonococcal colonies may vary in appearance as shown in the T3 colonies pictured here. |  |
N. gonorrhoeae colonies are pinkish-brown. The clear, golden-brown pigmentation apparent after incubation for 48 h. cultures results from autolysis of the cells. Compare with those of |  |
| Oxidase Test |  Oxidase-positive |
Acid only from glucose |  |
| Enzyme Substrate Test | Hydroxyprolylaminopeptidase +ve |
| Nitrate Reduction Test | Nitrate -ve |
Although strains of some organisms do not grow on medium on which polysaccharide is detected, polysaccharide may be detected in the growth inoculated onto the plate. N. gonorrhoeae does not produce polysaccharide from sucrose. | |
| Production of Deoxyribonuclease (DNase) |  DNase -ve |
Superoxol Test Superoxol +ve; all strains give 4+ reaction |  |
| Catalase Test (Reaction with 3% hydrogen peroxide) |  |
| Colistin-resistant |  Colisitin-resistant |
Species which may be misidentified as N. gonorrhoeae in acid detection tests
Depending on the acid detection test used, several strains of Neisseria and related species may be misidentified as N. gonorrhoeae; the biochemical characteristics of these species are shown in Table 2.
Table 2. Supplemental tests which permit differentiation among gram-negative diplococci that produce acid only from glucose.
| Species that produce acid only from glucose | Gram Stain | Enzyme substrate test | Nitrate Reduction | Colistin Resistance |
|---|---|---|---|---|
| N. gonorrhoeae | GND | Hydroxyprolylaminopeptidase +ve | - | R |
| K. denitrificans | GND | Hydroxyprolylaminopeptidase +ve | + | R |
| Maltose -ve N. meningitidis | GND | Gamma-glutamyl- aminopeptidase +ve | - | R |
| "N. kochii" | GND | Hydroxyprolylaminopeptidase +ve | - | R |
| N. cinerea | GND | Hydroxyprolylaminopeptidase +ve | - | (R) |
Abbreviations: GND, Gram-negative diplococcus; GNR, Gram-negative rod; +, most strains positive; -, most strains negative; R, strains grow well on selective medium for N. gonorrhoeae and/or show no inhibition around a colistin disk (10 micrograms); (R), most strains susceptible, some strains resistant.
Although enzyme substrate tests are intended to be used only for the identification of Neisseria spp. isolated on selective media for N. gonorrhoeae, isolates of other Neisseria spp. give the same reaction (hydroxyprolylaminopeptidase-positive) in this test as do isolates of N. gonorrhoeae. Thus, additional tests must be performed to differentiate between these species.
Table 3. Supplemental tests which permit differentiation among Neisseria and related species that produce hydroxyprolylaminopeptidase.
| Species that Produce Hydroxyprolylamino- peptidase | Cellular Elongation* | Acid from | Nitrate Reduction | Poly- saccharide from Sucrose | Superoxol | Colistin Resistance | ||||
|---|---|---|---|---|---|---|---|---|---|---|
| G | M | S | F | L | ||||||
| N. gonorrhoeae | Diplococci | + | - | - | - | - | - | - | Strong (4+) positive " explosive" | R |
| K. denitrificans | Rod filaments | + | - | - | - | - | + | - | - | R |
| N. gonorrhoeae subspecies kochii | Diplococci | + | - | - | - | - | - | - | Strong (4+) positive " explosive" | R |
| (N. cinerea) | Diplococci | - | - | - | - | - | - | - | Weak (2+) positive | (R) |
| N. subflava biovar subflava | Diplococci | + | + | - | - | - | - | - | Weak (2+) positive | S |
| N. subflava biovar flava | Diplococci | + | + | - | + | - | - | - | Weak (2+) positive | S |
| N. subflava biovar perflava | Diplococci | + | + | + | + | - | - | + | Weak (2+) positive | (R) |
| N. sicca | Diplococci | + | + | + | + | - | - | + | Weak (2+) positive | S |
| N. mucosa | Diplococci | + | + | + | + | - | + | + | Weak (2+) positive | S |
| (N. flavescens) | Diplococci | - | - | - | - | - | - | + | Weak (2+) positive | R |
Abbreviations: +, most strains positive; -, most strains negative; R, strains grow well on selective medium for N. gonorrhoeae and/or show no inhibition around a colistin disk (10 micrograms); (R), most strains susceptible, some strains known to be resistant; S, strains susceptible, no strains known to be resistant.
Reporting
For reporting purposes, the laboratory should perform species-level identification/confirmation in order to report a definitive result for the clinician unless otherwise requested.
A Confirmed/Definitive report of "N. gonorrhoeae isolated" may ONLY be made when an isolate has been identified to the species level with sufficient tests to ensure the accuracy of the identification i.e., compensating for the problems associated with rapid tests.
A report of "gram-negative, oxidase-positive diplococcus isolated" should be made if the organism suspected to be N. gonorrhoeae has:
typical gram-negative intracellular diplococci on microscopic examination of a smear of urethral exudate (men) of endocervical secretions (women); or
- an organism with typical colonial morphology, positive oxidase reaction, and typical gram-negative cell morphology is grown from the urethra (men) or endocervix (women) on culture medium.
A report of "presumptive N. gonorrhoeae" or, ideally, to avoid confusion, "gram-negative, oxidase-positive diplococcus isolated" should be made if identification of the organism suspected to be N. gonorrhoeae is based on:
- identification of a strain from any site with a rapid test with which problems are known to exist, such as
- acid production tests that may give false-positive or -negative acid reactions, particularly from glucose, e.g., N. cinerea;
- use of enzyme substrate tests to identify Neisseria species that normally would not be expected to grow on selective media for N. gonorrhoeae including strains of N. cinerea, B. catarrhalis, and N. subflava biovar perflava but which, occasionally, are isolated on selective media.
- inappropriate [off-label] use of the test such as use of enzyme substrate tests to identify strains isolated on nonselective media.
- detection of N. gonorrhoeae by a nonculture laboratory test such as an antigen detection test (e.g., Gonozyme), nucleic acid probe test (GenProbe), or a nucleic acid amplification test (LCR, PCR).
In the case of presumptive identifications, it is important that the clinician receiving this report understands that additional tests may be required to confirm a presumptive identification before medicolegal actions are taken.
Medicolegal Issues Related to the Identification of N. gonorrhoeae
Information regarding evaluation of adults, adolescents, and children for sexually transmitted diseases acquired as a result of sexual assault or abuse are available in the section entitled SEXUAL ASSAULT AND STDs in the 2002 STD Treatment Guidelines published by CDC.
Because investigations of sexual abuse may be initiated on the basis of a laboratory diagnosis of gonorrhea, only definitive/confirmed identifications of N. gonorrhoeae should be accepted by a clinician. Such identifications should only be made only on the basis of identification of an isolate of N. gonorrhoeae in a standard culture. Isolates should be identified by at least two (2) tests that involve different principles (e.g., biochemical, serological, or nucleic acid probe culture confirmation tests) and take into account additional tests that should be performed to compensate for problems known to be associated with the primary confirmation tests. Isolates should be preserved in case additional or repeated testing is needed.
Presumptive identifications of N. gonorrhoeae are not, in themselves, sufficient for medicolegal purposes; isolates presumptively identified as N. gonorrhoeae should be identified as described above.
Laboratorians are reminded that problems have been identified with most tests for the rapid identification of N. gonorrhoeae. Laboratorians should be familiar with these problems, and with supplemental tests that should be performed to confirm the identity of an isolate as N. gonorrhoeae.
References
Baron EJ., Cassell GH, Duffy LB, Eschenbach DA, Greenwood JR, Harvey SM, Madinger NE, Peterson EM, Waites KB. 1993. Cumitech 17A: Laboratory Diagnosis of Female Genital Tract Infections. Coordinating ed. EJ Baron. American Society for Microbiology, Washington, D.C.
Bovre K. 1984. Family VIII. Neisseriaceae Prevot, p. 288-309. In NR Krieg (ed.). Manual of Systematic Bacteriology, vol. 1. The Williams & Wilkins co., Baltimore.
Evangelista AT, Beilstein HR. 1993. Cumitech 4A: Laboratory Diagnosis of Gonorrhea. Coordinating ed. C. Abramson. American Society for Microbiology, Washington D.C.
Knapp JS. Historical perspectives and identification of Neisseria and related species. Clin Microbiol Rev 1988;1:415-431.
Knapp JS, Rice RJ. Neisseria and Branhamella. In. Murray PR, Baron EJ, Pfaller MA, Tenover FC, Yolken RH. (ed.). Manual of Clinical Microbiology. 6th ed. American Society for Microbiology, Washington DC, 1995.
Vedros NA. 1984. Genus I. Neisseria Trevisan 1885, 105AL, p. 290-296. In N. R. Krieg (ed.). Bergey's Manual of Systematic Bacteriology, vol. 1. The Williams & Wilkins Co., Baltimore.
- Page last reviewed: December 10, 2013
- Page last updated: October 17, 2008
- Content source:


 ShareCompartir
ShareCompartir